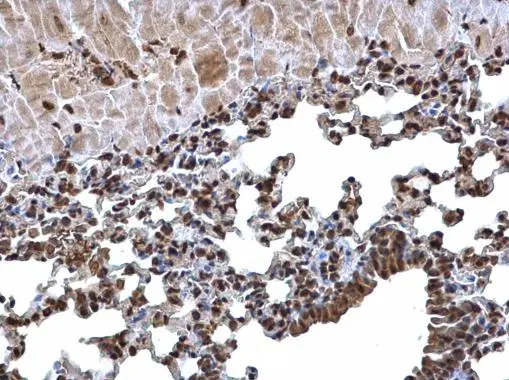
Histone H3 antibody detects Histone H3 protein at nucleus on mouse lung by immunohistochemical analysis. Sample: Paraffin-embedded mouse lung. Histone H3 antibody (GTX129546) dilution: 1:500. 
 Antigen Retrieval: Trilogy? (EDTA based, pH 8.0) buffer, 15min

Whole cell extract (30 μg) was separated by 15% SDS-PAGE, and the membrane was blotted with Histone H3 antibody (GTX129546) diluted at 1:1000. The HRP-conjugated anti-rabbit IgG antibody (GTX213110-01) was used to detect the primary antibody.
Histone H3 antibody
GTX129546
ApplicationsWestern Blot, ImmunoHistoChemistry, ImmunoHistoChemistry Paraffin
Product group Antibodies
ReactivityDrosophila, Human, Mouse, Rat
TargetH3C1
Overview
- SupplierGeneTex
- Product NameHistone H3 antibody
- Delivery Days Customer9
- Application Supplier NoteWB: 1:500-1:3000. IHC-P: 1:100-1:1000. *Optimal dilutions/concentrations should be determined by the researcher.Not tested in other applications.
- ApplicationsWestern Blot, ImmunoHistoChemistry, ImmunoHistoChemistry Paraffin
- CertificationResearch Use Only
- ClonalityPolyclonal
- Concentration1 mg/ml
- ConjugateUnconjugated
- Gene ID8350
- Target nameH3C1
- Target descriptionH3 clustered histone 1
- Target synonymsH3/A, H3C10, H3C11, H3C12, H3C2, H3C3, H3C4, H3C6, H3C7, H3C8, H3FA, HIST1H3A, histone H3.1, H3 histone family, member A, histone 1, H3a, histone H3/a, histone cluster 1 H3 family member a, histone cluster 1, H3a
- HostRabbit
- IsotypeIgG
- ReactivityDrosophila, Human, Mouse, Rat
- Storage Instruction-20°C or -80°C,2°C to 8°C
- UNSPSC12352203
References
- Wijenayake S, Storey KB. The role of DNA methylation during anoxia tolerance in a freshwater turtle (Trachemys scripta elegans). J Comp Physiol B. 2016,186(3):333-42. doi: 10.1007/s00360-016-0960-xRead this paper